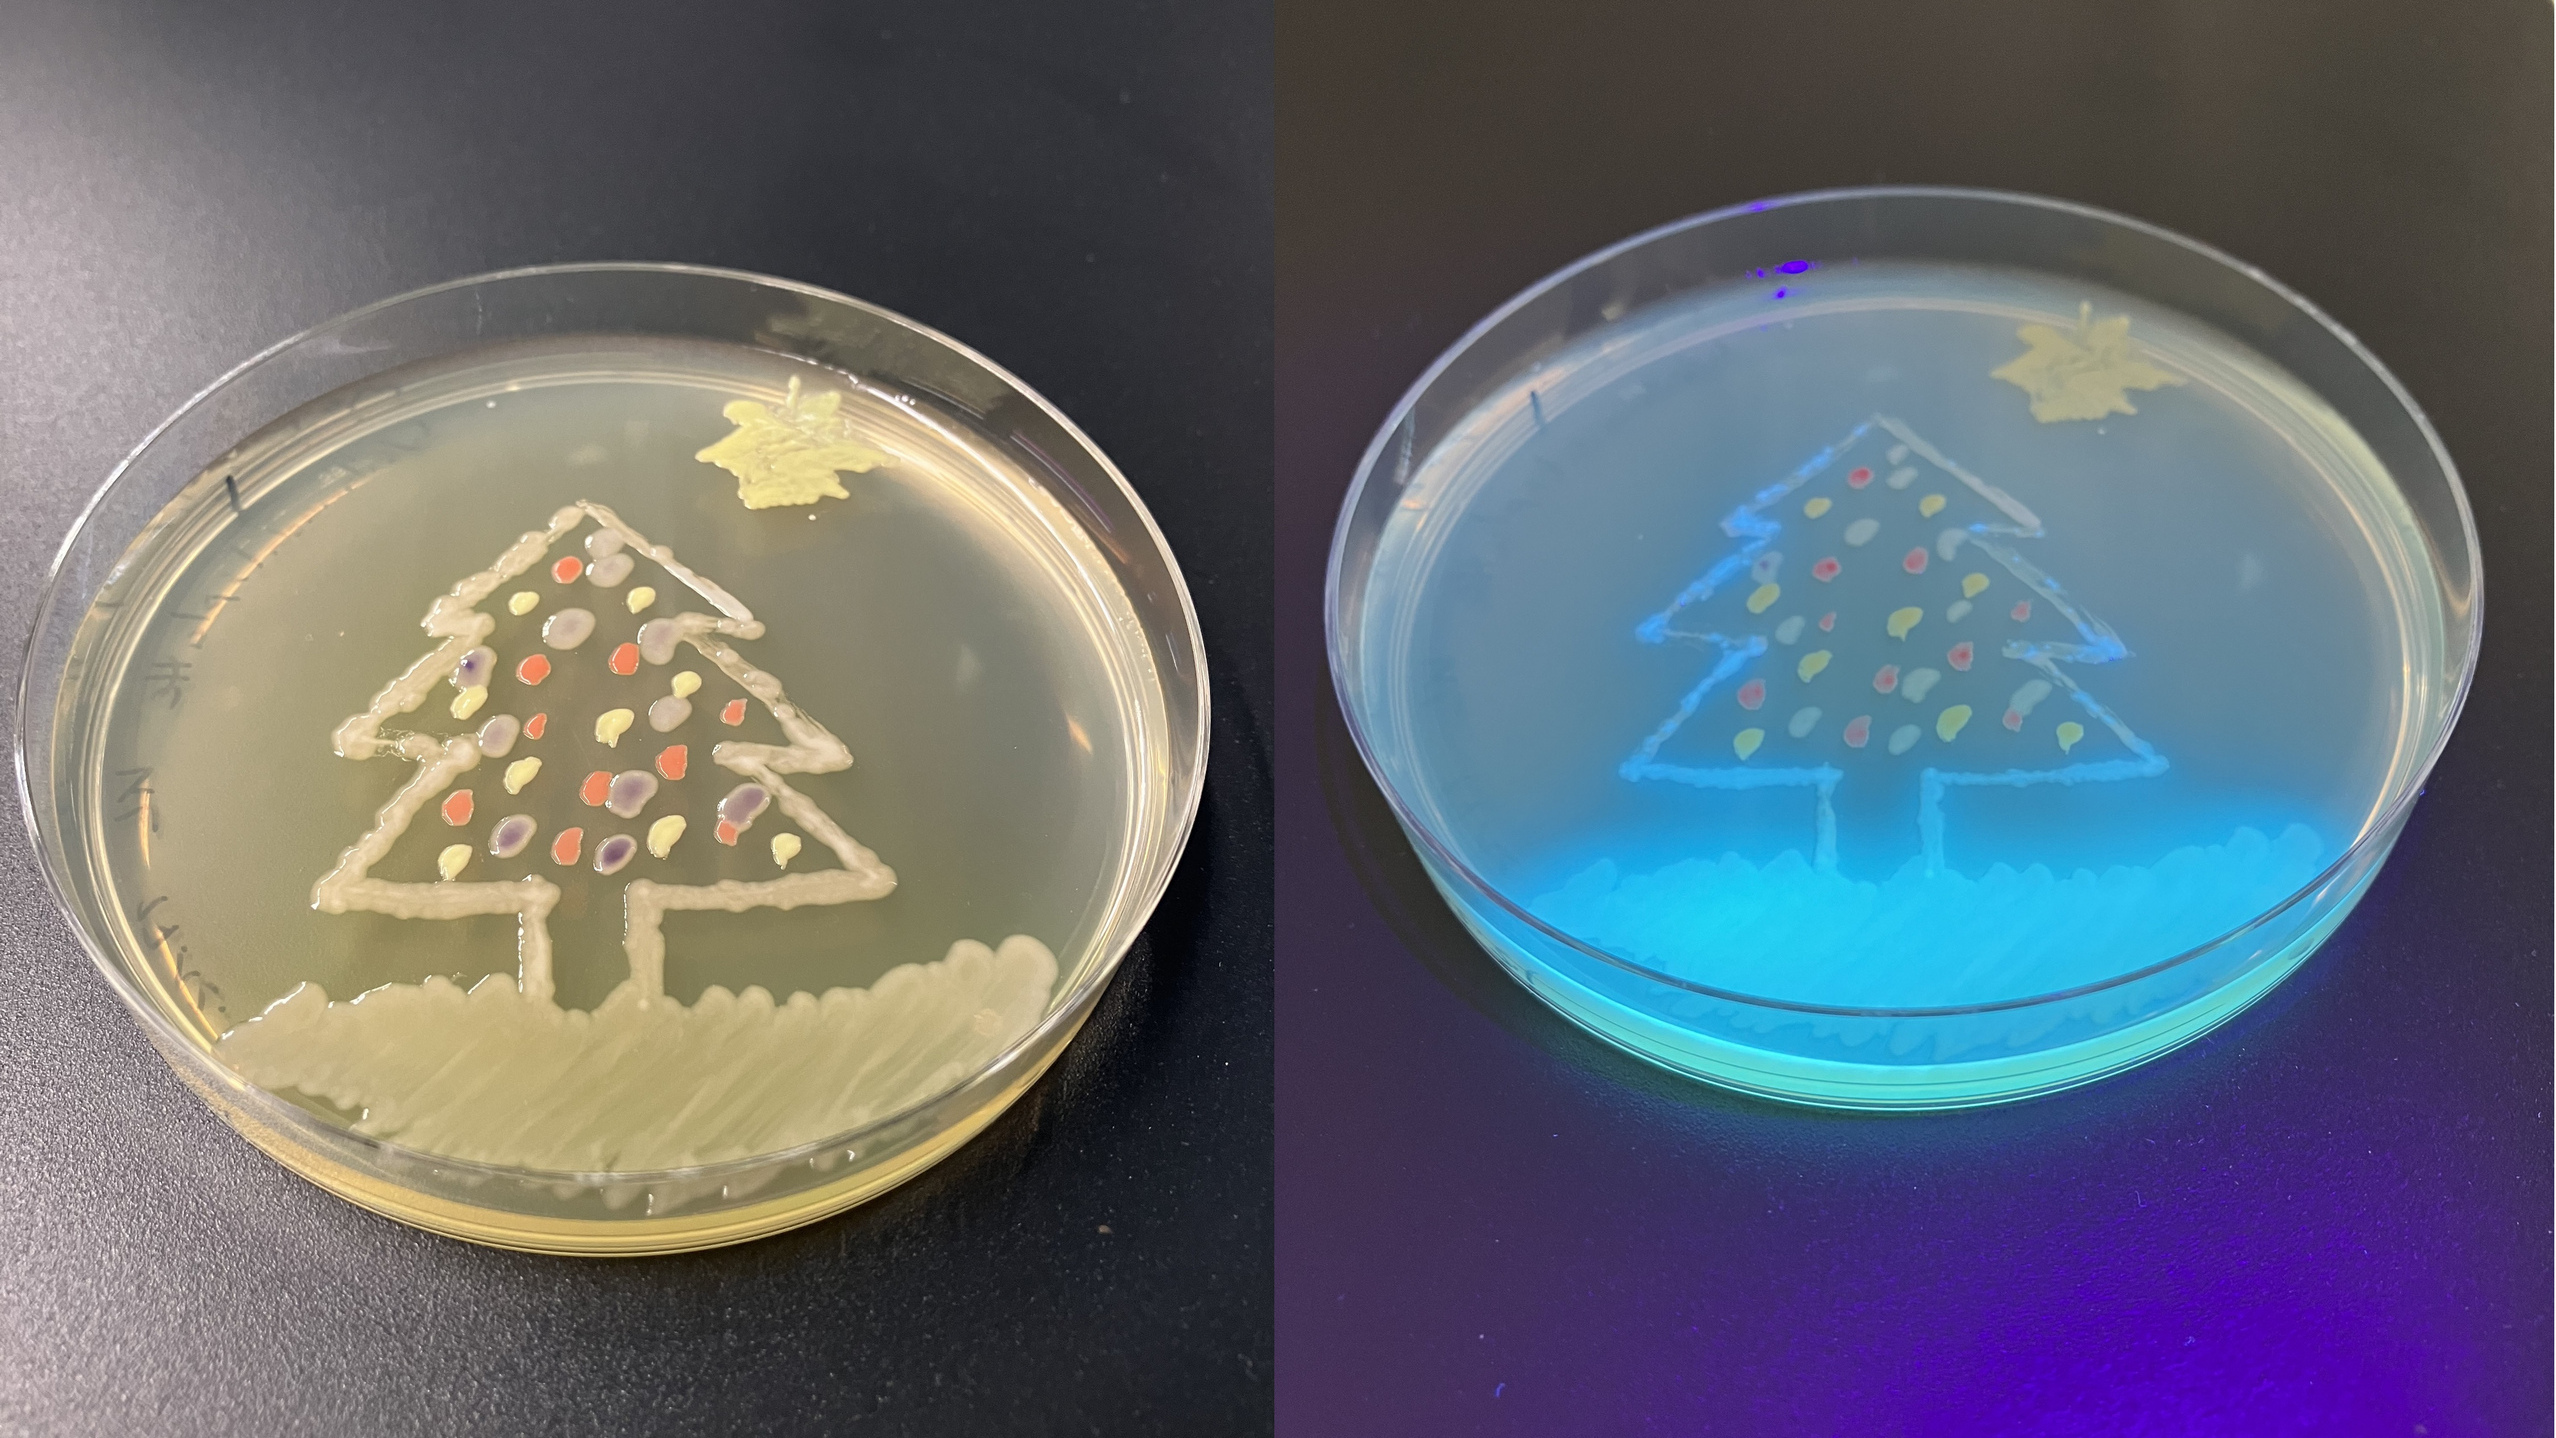
Foto aus dem labor

Mikrobielle Biotechnologie
Themen und Schwerpunkte
Mikrobiologische Arbeiten mit Bakterien, Hefen und Schimmelpilzen
Kultivierung von Bakterien + Hefen : Von der Agarplatte bis zum 10 Liter Bioreaktor
Entwicklung von Bioreaktorsystemen und low-cost Messeinrichtungen
Entwicklung und Automatisierung von Prozessführungsstrategien
Optimierung von Wachstumsfaktoren (Medium, Substrate, pH, Temperatur, etc.)
Ausstattung
Alles für das hygienische/sterile Arbeiten mit Mikroorganismen im Labor
Lichtmikroskope und Stereomikroskop mit Kamerasystem
8-fach Multifermentationssystem 0,2 Liter
2 Liter Glasbioreaktor mit umfangreicher Messtechnik
10 Liter Edelstahlbioreaktor mit Siemens Automationssystem und umfangreicher Messtechnik
Kontakt
Prof. Dr. Kai Lögering
Kommunikation
Stephanstraße 7
64295 Darmstadt
Büro: B15, 02.04